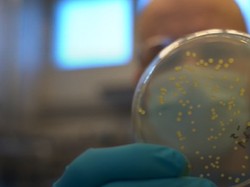
Perusahaan Asal Finlandia Kembangkan Makanan Buatan dari Udara

detikNews
Aktivis Perempuan Semangati Puan, Dukung RUU TPKS Segera Dirampungkan
Ustazah dari Kongres Ulama Perempuan Indonesia Nur Rofiah sampaikan aspirasi terkait RUU Tindak Pidana Kekerasan Seksual kepada Ketua DPR RI, Puan Maharani.
Kamis, 13 Jan 2022 08:43 WIB